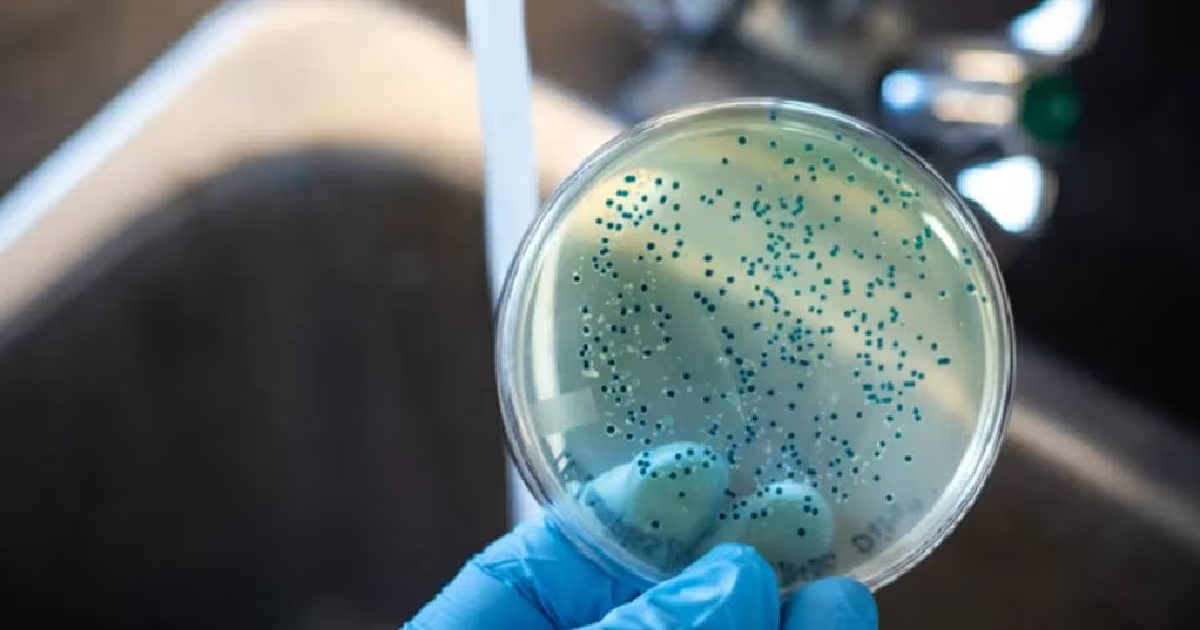

Новини за 23.05.2025

На Закарпатті викрито митника, який заробляв на «контрабанді» чоловіків призовного віку
Інспектор митної служби Закарпатської області намагався налагодити схему незаконного переправлення чоловіків призовного віку за кордон.
19:19 23.052025
Події
10012

В Ужгороді відбулася регіональна зустріч «Реімбурсація «Доступні ліки» 2025»
В Ужгороді відбулася регіональна зустріч «Реімбурсація «Доступні ліки» 2025», організована Національною службою здоров’я України
19:18 23.052025
Життя
2456

37-річний закарпатець зарізав 63-річного батька
Іноді на Закарпатті стаються моторошні злочини. Страшно, коли рідні діти позбавляють життя своїх батьків. Загалом будь-яка форма насильства є неприпустимою, але знущання над близькими взагалі не вкладається у будь-яку логіку.
18:55 23.052025
Події
4621

Скільки коштує озеленення і які суми закарпатці витрачають на квіти
Весна добігає кінця і нарешті погода радує теплом. Краяни активно займаються благоустроєм подвір’їв, лоджій і балконів. Кожному хочеться створити довкола себе красу
18:31 23.052025
Економіка
4314

На Закарпатті відбувся Загальноукраїнський форум виноробів
Винороби з усієї країни зібралися сьогодні на Закарпатті для участі у Загальноукраїнському форумі виробників виноробної продукції.
18:07 23.052025
Життя
2745

Відбулася зустріч українсько-угорської робочої групи із захисту від шкідливої дії вод
У межах виконання двосторонньої українсько-угорської Міжурядової Угоди з питань водного господарства на прикордонних водах 20-22 травня 2025 року відбулася зустріч спільної робочої групи Сторін із захисту від шкідливої дії вод.
17:59 23.052025
Життя
9208

На Нижніх воротах під час перевірки авто виявили правопорушення
Учора, близько 19-ї години, під час несення служби екіпаж патрульної поліції на дорожній станції "Нижні ворота" зупинив транспортний засіб Medcedes-Benz.
17:39 23.052025
Події
1801

У Перечині знешкодили мінометну міну часів Другої світової війни
22 травня о 10:10 до Служби порятунку надійшло повідомлення про виявлення вибухонебезпечного предмета на вулиці Мілана Шашіка у місті Перечин Ужгородського району.
17:09 23.052025
Події
999

Наче живі. Хустянка створює реалістичних птахів
Яка весна без пернатих? Це – пора, коли додому, до рідного гнізда повертаються усі птахи. А у хустянки Емілії Сайберт птахи поруч цілий рік.
16:44 23.052025
Життя
7474

У Закарпатській обласній зі шлунка 6-місячної дівчинки видалили заколку для волосся
До Закарпатської обласної дитячої лікарні потрапила 6-місячна дівчинка вагою 7 кг, яка випадково проковтнула заколку для волосся.
16:21 23.052025
Події
1711
Перевірка якості води на Закарпатті: 30% водопроводів не відповідають санітарним нормам
Відповідно до інформації Закарпатської обласної військової адміністрації, епідемічна ситуація в регіоні залишається напруженою, особливо щодо інфекцій, пов’язаних із якістю питної води та санітарним станом територій.
16:09 23.052025
Життя
5005

«Фортеця духу»: в Ужгородському замку ветерани навчатимуть стрільбі з лука
В Ужгородському замку відкрили простір для стрільби з лука. «Фортеця духу» - це спільний проєкт Федерації адаптивних видів спорту та Закарпатського краєзнавчого музею ім. Тиводара Легоцького.
15:10 23.052025
Життя
1800

Відкриття програми «Дейріне» на Закарпатті увінчав театральний галаконцерт
Відкриття підпрограми «Без кордонів» культурної програми "Дейріне" увінчалося 20 травня урочистим галаконцертом в Закарпатському обласному угорському драматичному театрі
14:47 23.052025
Життя
1159

Національний тиждень безбар’єрності в Закарпатті: візит до «Янгола»
В інклюзивній майстерні-кавʼярні «Янгол» – чимало оновлень: і в асортименті того, чим можна тут посмакувати, і в кількості майстер-класів для всіх охочих, і на другому поверсі, де працюють над тим, аби могти надавати послугу підтриманого проживанн...
14:25 23.052025
Життя
1611

Закарпаття із візитом відвідав Посол КНР
На Закарпатті з першим офіційним візитом перебуває Надзвичайний і Повноважний Посол Китайської Народної Республіки Ма Шенкунь.
13:40 23.052025
Політика
3407

Близько 370 осіб з інвалідністю скористалися послугами Закарпатської служби зайнятості з початку року
Цьогоріч послугами Закарпатської обласної служби зайнятості скористалося 366 осіб з інвалідністю.
13:25 23.052025
Життя
1240

Закарпатські гандболістки проведуть заключні матчі чемпіонату України
Завершальні матчі чемпіонату не мають турнірної ваги для ужгородських «Карпат». Колектив Бориса Петровського ще напередодні забронював за собою срібні медалі. Відомий також чемпіон («Галичанка» Львів) та бронзовий призер («Спартак-ШВСМ» Київ).
13:14 23.052025
Спорт
1389

Понад 114 тисяч грн зібрали на благодійному ярмарку в Ужгороді для порятунку життя трирічної Емілії
Благодійний ярмарок організували викладачі й студенти Ужгородського торговельно-економічного фахового коледжу, аби долучитися до порятунку життя 3-річної Емілії, батько якої викладає в цьому начальному закладі.
12:40 23.052025
Життя
1816

На Закарпатті з’явиться Центр ментального здоров’я для дітей та підлітків
У Мукачеві планують створити Центр ментального здоров’я на базі Закарпатської обласної дитячої лікарні. Ініціатива реалізується спільно благодійним фондом «Карітас Чеської Республіки», Закарпатською обласною радою та ОВА. Про це йшлося під час зус...
12:25 23.052025
Життя
1955

Трьох порушників кордону відшукали прикордонники у високогір’ї за допомогою безпілотника
Молодиків, які заблукали в горах, знайшли вчора прикордонники відділення «Богдан» Мукачівського загону разом із гірськими рятувальниками ДСНС.
11:56 23.052025
Події
1581

В Ужгороді провели Кубок області з міжнародних шашок-64
Змагання, які нещодавно відбулися у СК «Юність», зібрали 14 спортсменів з Ужгорода, Перечина, Іршави, Виноградова, Хуста, Маріуполя, Харков та Ужгородського району.
11:38 23.052025
Спорт
2742

На Тячівщині відбудеться автопробіг пам’яті Героїв
Усіх небайдужих запрошують долучитися до вшанування Захисників, які віддали життя за Україну, автопробігом у Тячівському районі Закарпатської області.
11:09 23.052025
Життя
1966

Через провал земної породи і просадку колії тимчасово перекрито рух на дільниці Ясіня-Вороненко
У Рахівському районі Закарпатської області триває відновлення дорожнього полотна, яке було пошкоджено через просідання гірської породи.
10:49 23.052025
Події
1424

Мукачівська школа мистецтв імені Степана Мартона відзначила 80-річчя
10:33 23.052025
Життя
1902

Україна та Чехія посилюватимуть стратегічне партнерство
Про це йшлося на зустрічі премʼєр міністрів Дениса Шмигаля та Петера Фіали, яка відбулася на Ужгородщині.
10:00 23.052025
Політика
16961

Закарпатський народний хор долучився до проведення Національного тижня безбар’єрності
У рамках цієї ініціативи 22 травня Заслужений академічний Закарпатський народний хор під орудою художнього керівника та головного диригента Наталії Петій-Потапчук приймав у своєму хоровому класі гостей – Колектив підготував велику концертну програму
09:45 23.052025
Життя
2051

В Ужгороді відбулися матчі в зоні «Захід» юнацького чемпіонату України з регбі-7
До дорослого регбі через регбі-7. Саме з цього різновиду популярної у світі гри в Ужгороді відбулися матчі в зоні «Захід» чемпіонату України з-поміж юнаків 2011–2012 років народження.
09:30 23.052025
Спорт
6858
| Пн | Вт | Ср | Чт | Пт | Сб | Нд |
|---|---|---|---|---|---|---|
| 1 | 2 | 3 | ||||
| 4 | 5 | 6 | 7 | 8 | 9 | 10 |
| 11 | 12 | 13 | 14 | 15 | 16 | 17 |
| 18 | 19 | 20 | 21 | 22 | 23 | 24 |
| 25 | 26 | 27 | 28 | 29 | 30 | 31 |